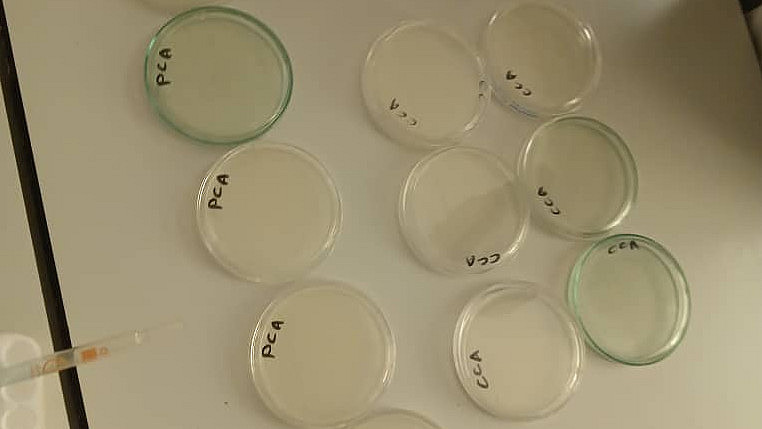

News & Outreach
Project Update September 2025: SUSCAMI Team Presents at Tropentag 2025 Conference
The SUSCAMI team from the University of Kassel is pleased to share the latest news from the Tropentag conference, which took place in Bonn this year. PhD student Hassan Hassanuur Kalla represented the team and presented the first exciting results of the baseline survey conducted in 2024, as well as insights into the health status and management of camels during the dry season of 2025 (for Berhanu Wakjira, PhD student of Addis Ababa University).
During the guided poster tour, the SUSCAMI team engaged in valuable discussions with conference participants, exchanging ideas and gaining valuable feedback on their research. This event marked a significant milestone in the project's progress, and we are grateful for the opportunity to share our findings with the international community.
We would like to extend our gratitude to Hassan Hassanuur Kalla for his outstanding presentations and to the Tropentag conference organizers for providing a platform for knowledge sharing and collaboration.
Stay tuned for more updates from the SUSCAMI project!
Update June 2025: Completion of First-Round Interviews in Borana zone
First insights gained in relation to the organization and economics of the camel milk value chain in the wet season
We are pleased to announce that the interviews to identify actors and their interrelations along the camel milk value chain in the Borana area have been completed. Our MSc student from Arsi University, Abdulsemed, has successfully conducted in-depth interviews with 192 camel milk producers, 16 milk collectors, 20 retailers, and 30 camel milk consumers from Yabelo, Gomole, and Elwaye districts (tasks 4.1 & 4.2).
These interviews have provided valuable insights into the income generation of these actors during the wet season, shedding light on the dynamics of the camel milk value chain up to Moyale, Kenya. We would like to extend our congratulations to Abdulsemed for his outstanding work in collecting this rich data.
The next phase of the study will take Abdulsemed to the East Shewa zone, where he will continue to gather data and build on the findings from the Borana area. We wish him all the best for this next stage of his research and look forward to sharing the results of this project with you in the coming months.
Project Update May 2025: Progress on Milk Handling Practices and Microbial Contamination of Camel Milk
We are pleased to report significant progress on task 4.3 (Milk handling practices) and task 4.4 (Microbial contamination of camel milk) of our ongoing SUSCAMI project. Our dedicated team, Berhanu Wakjira and Geletu Gudeta Dekebo from Addis Ababa University, has commenced the assessment of milk handling practices and sampling/analysis of milk samples to evaluate microbial contamination of camel milk along the entire milk value chain in the Borana study zone during the main wet season.
Field work is expected to continue until the beginning of June. During this period, the AAU team will be conducting thorough assessments of milk handling practices and collecting milk samples from various points along the milk value chain. These samples will then be analyzed to determine the levels of microbial contamination.
Following the completion of field work in the Borana zone, the AAU team will proceed to the East Shewa zone to conduct the same assessments. This will enable us to gather a comprehensive understanding of milk handling practices and microbial contamination of camel milk across different regions.
We will continue to provide regular updates on the progress of our project. Please visit our webpage for the latest news and developments.
Thank you for your interest in our project!
April 2025: Observation of camels' wet-season feed preferences, performances and health conditions underway in Borana Study Area
Following the successful focus group discussions in February, our team has made significant progress in the field. Hassan Kalla, PhD student from Universit of Kassel (UKS), has commenced observing the feed preferences of camels in the Borana study area (task 2.3). This crucial research aims to better understand the dietary habits of these facinating animals.
In parallel, our team has initiated wet-season milk and performance recording, as well as health assessments of lactating female camels and their calves. Furthermore, Abdulsemed Aman Edoshe, under the supervision of Borana University (BrU) started his data collection on the organizational structure and functionality of the camel milk value chain, as well as income generation along the value chain in that area (task 4.1 & 4.2).
These activities will continue until the end of May, providing valuable insights into the nutritional and health needs of camels in this region.
March 2025: New Master Studies Set to Shine Light on Camel Milking Practices and Value Chain
We are happy to announce the commencement of two Master's studies. The investigations will focus on the camel milk value chain, aiming to enrich understanding and optimization of milking practices and milk hygiene.
The first study, "Investigation of Camel Milk Handling Practices, and Bacteriological Quality Along the Value Chain" will closely scrutinize the handling practices of camel milk, as well as determining its bacteriological quality. This work will be overseen by Addis Ababa University (AAU), and co-supervised by Borana University (BrU) and the University of Kassel (UKS).
The second study, "Organizational Structure and Functionality of Camel Milk Value Chain and Income Generation," will delve into the infrastructure and profitability of the camel milk industry in the two study sites. This research will be supervised by BrU, and co-supervised also by UKS.
These research studies align with our ongoing Work Package 4 (WP4), "Analysis of the Camel Milk Value Chain". The findings are expected to address critical gaps in knowledge and contribute significantly to the camel milk value chain comprehension in the region.
Stay tuned for updates and insights from these pivotal studies. We look forward to sharing our progress and discoveries with you over the next 12 months.
February 2025: Activities of Task 2.3 "Camels' most preferred forage feed and their nutritional profile" initiated
In February 2025, the team of UKS initiated the activities of task 2.3. In this task, camels' most preferred forage feed and their nutritional profile will be assessed. Two and three focus group discussions with purposively selected experienced camel herders have been conducted in Borana and East Shewa study zone, respectively. Structured question guidelines and feed resource maps were used to identify the most preferred forage species by camels, as stated by the herders. The perceived importance was used to rank the identified species. Following the FGD, field observations of camels' feeding behavior, and sampling and subsequent laboratory analysis of the wild plant species that are most frequently consumed by the camels will be performed. These activities will start in April 2025 in Borana zone.
January 2025: Dry season monitoring of camel herds completed in East Shewa and Borana zone
The two doctoral researchers, with the support of local stakeholders and students, completed the monitoring of 48 camels herds in the two study zones. In total, the re-/productive performances and (udder) health condition of 132 female camels have been assessed; in addition, the infestation of the females and their calves (n=130) with gastrointestinal nematodes were evaluated. The monitoring of camels will now be followed by the collection of monthly milk records until October 2025.
Presentation of the SUSCAMI project at the GFFA 2025
Dr. Regina Roessler, coordinator of the SUSCAMI project and senior researcher at the University of Kassel, presented the SUSCAMI project (funded by BMEL through BLE) at the cluster and network meeting "Grouping, Cooperation & Value Chains" organized by GFA during the Global Forum for Food and Agriculture (GFFA) 2025 in Berlin.
Monitoring of camels' re-/productive performances and health status started in November 2024 (East Shewa) and December 2024 (Borana)
Following the surveys to assess husbandry and health care management of camels of pastoralists from East Shewa and Borana zone, the two doctoral researchers, Berhanu Wakjira (Addis Ababa University) and Hassan Hassanuur Kalla (University of Kassel) started monitoring of camels' re-/productive performances (Task 2.2) and health status (Task 3.2) in November (East Shewa) and December (Borana), respectively.
September 2024: Joint interviews on camel husbandry, feeding and health management in Borana and East Shewa zone completed
From June until September 2024, the first research activities within the SUSCAMI project have been conducted. In total, 386 camel herders from Fantale district (East Shewa zone) and from different districts in Borana zone were interviewed to assess the husbandry, feeding, breeding and health care management of camels (Tasks 2.1 and 3.1). Data will serve to define criteria to select camel herds for monitoring of camels' re-/productive performances (Task 2.2) and health status (Task 3.2) as well as feeding behavior (Task 2.3) planned for the main dry and rainy season of 2024 / 2025.